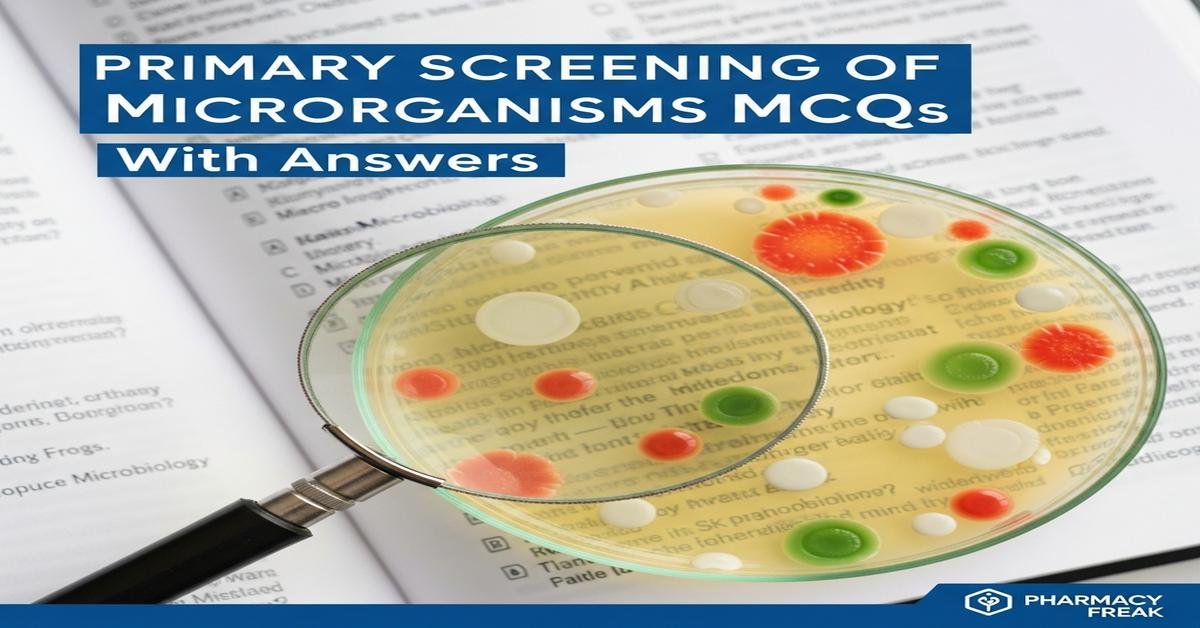
Primary screening of microorganisms MCQs With Answer

Introduction: Primary screening of microorganisms is a fundamental step in bioprocess engineering, where diverse environmental isolates are evaluated to identify strains with desirable biochemical or pharmaceutical traits. For M.Pharm students, mastering primary screening methods—such as selective/enrichment cultures, plate assays, indicator media, and zone-of-inhibition tests—is essential for discovering antibiotic producers, enzyme-secreting microbes, and metabolite-rich strains. This blog presents targeted MCQs to reinforce concepts like selective media design, screening assays, high-throughput techniques, and criteria for promising industrial strains. These questions emphasize practical decision-making, experimental interpretation, and critical factors that influence successful isolation and preliminary characterization of microbial candidates for drug development and bioprocessing.
Q1. Which primary screening method is most appropriate to selectively enrich actinomycetes from soil samples?
- Direct plating on nutrient agar without pretreatment
- Heat treatment of soil followed by plating on starch casein agar
- Filtration through 0.22 µm membrane and plating
- Incubation in anaerobic enrichment broth
Correct Answer: Heat treatment of soil followed by plating on starch casein agar
Q2. In primary screening for extracellular protease producers, which plate assay provides a rapid visual indication?
- Blue-white screening on X-gal plates
- Clear zone formation on skim milk agar
- Growth on mannitol salt agar
- Hemolysis on blood agar
Correct Answer: Clear zone formation on skim milk agar
Q3. Which of the following describes the main purpose of an enrichment culture in primary screening?
- To measure the exact yield of a metabolite in a pure culture
- To increase the relative abundance of organisms with the desired activity
- To sterilize the sample before analysis
- To inhibit growth of the target organism
Correct Answer: To increase the relative abundance of organisms with the desired activity
Q4. Replica plating is most useful in primary screening for identifying colonies that:
- Grow faster than all others on rich medium
- Carry plasmids based on colony color alone
- Lose or gain a selectable trait when transferred to different media
- Have identical colony morphology
Correct Answer: Lose or gain a selectable trait when transferred to different media
Q5. Which indicator dye is commonly used to screen for acid-producing fermentative microbes on agar plates?
- Phenol red
- Coomassie Brilliant Blue
- Crystal violet
- Triphenyl tetrazolium chloride (TTC)
Correct Answer: Phenol red
Q6. For screening antibiotic-producing bacteria, which technique provides a direct measure of antibiotic activity against a test organism?
- Gram staining of isolated colonies
- Cross-streak or agar diffusion assay showing zones of inhibition
- Observation of pigmentation on agar
- Measurement of colony diameter over time
Correct Answer: Cross-streak or agar diffusion assay showing zones of inhibition
Q7. Which medium property makes it ‘selective’ in primary screening?
- It supports growth of all microbes equally
- It contains components that inhibit unwanted organisms while permitting target growth
- It is always solidified with gelatin
- It is transparent for easy observation
Correct Answer: It contains components that inhibit unwanted organisms while permitting target growth
Q8. Which of the following is a high-throughput approach increasingly used in primary screening of microbial libraries?
- Single-colony streaking on plates manually
- Microtiter plate assays with automated readers
- Manual spot plating with eye inspection
- Large-volume shake flask screening only
Correct Answer: Microtiter plate assays with automated readers
Q9. When screening for lipase activity on agar plates, which substrate is commonly incorporated to visualize hydrolysis?
- Casein
- Tween or tributyrin
- X-gal
- Starch
Correct Answer: Tween or tributyrin
Q10. In primary screening for cellulase-producing microbes, the use of Congo red staining on CMC (carboxymethyl cellulose) plates identifies colonies by:
- Forming pigmented colonies due to dye uptake
- Creating clear halos after dye wash indicating cellulose hydrolysis
- Changing colony shape from circular to irregular
- Inducing fluorescence under UV
Correct Answer: Creating clear halos after dye wash indicating cellulose hydrolysis
Q11. Which criterion is NOT commonly used to prioritize strains after primary screening for industrial development?
- High specific activity of the desired product
- Genetic stability over successive generations
- Ability to colonize human tissues rapidly
- Compatibility with downstream processing
Correct Answer: Ability to colonize human tissues rapidly
Q12. Which primary screening method helps detect secreted secondary metabolites without destroying colonies?
- Overlay assay using a susceptible indicator organism
- Complete lysis of colonies followed by extraction
- Direct microscopic staining of colonies
- Boiling the plate to release metabolites
Correct Answer: Overlay assay using a susceptible indicator organism
Q13. During dilution plating for primary screening, the main purpose of serial dilution is to:
- Increase the nutrient concentration
- Obtain well-separated colonies for isolation
- Change the pH of the medium
- Reduce incubation time drastically
Correct Answer: Obtain well-separated colonies for isolation
Q14. Which approach is most suitable for primary screening of strains producing intracellular enzymes rather than extracellular ones?
- Assaying culture supernatant directly on plates
- Lysing cells and assaying cell extracts in microtiter plates
- Using halo formation on agar
- Overlaying indicator organism on top of the culture plate
Correct Answer: Lysing cells and assaying cell extracts in microtiter plates
Q15. Which of the following is a limitation of plate-based primary screening methods?
- They can directly quantify intracellular metabolite concentration
- They may miss slow-growing or non-culturable but valuable organisms
- They are always more sensitive than liquid assays
- They provide definitive taxonomic identification
Correct Answer: They may miss slow-growing or non-culturable but valuable organisms
Q16. Use of chromogenic substrates in screening is advantageous because they:
- Require radioactive detection methods
- Provide color change upon enzymatic activity for easy visual scoring
- Completely inhibit non-target microbes
- Are only useful for antibiotic detection
Correct Answer: Provide color change upon enzymatic activity for easy visual scoring
Q17. To reduce false positives in screening for antimicrobial producers, which control is most important?
- Including an uninoculated medium control and a known non-producer strain
- Only using a single test organism without controls
- Incubating at room temperature without replication
- Using turbidimetric measurement only
Correct Answer: Including an uninoculated medium control and a known non-producer strain
Q18. Which technique allows comparative screening of thousands of mutants for improved metabolite production with minimal media volume?
- Large-volume bioreactors with manual sampling
- Microplate-based high-throughput screening with colorimetric assays
- Single agar plate per mutant
- Electron microscopy screening
Correct Answer: Microplate-based high-throughput screening with colorimetric assays
Q19. Which statement best describes the role of osmotic or chemical selection agents in selective media during primary screening?
- They enhance growth of all environmental microbes equally
- They favor survival or growth of organisms with specific resistance or metabolic capabilities
- They solely change colony color without affecting growth
- They sterilize the medium to prevent contamination entirely
Correct Answer: They favor survival or growth of organisms with specific resistance or metabolic capabilities
Q20. When designing a primary screen for a novel antibiotic that targets Gram-negative bacteria, which strategy increases the chance of finding producers?
- Screen only organisms isolated from sterile environments
- Include Gram-negative indicator strains in overlay assays and use media favoring actinomycetes or soil bacteria
- Use only nutrient-poor water agar without indicators
- Avoid any selective pressure during isolation
Correct Answer: Include Gram-negative indicator strains in overlay assays and use media favoring actinomycetes or soil bacteria